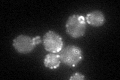
YNL084C
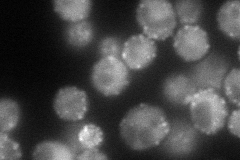
YNL084C
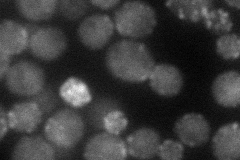
YNL084C
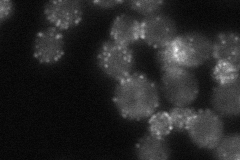
YNL084C
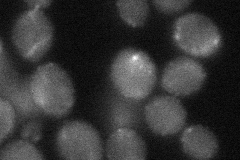
YNL084C

View description
EH domain-containing protein involved in endocytosis, actin cytoskeletal organization and cell wall morphogenesis; forms a complex with Sla1p and Pan1p
Localization:
Intensity:
Fold change:
Significance:
-
C’ GFP library in SD
punctate51.68 -
N' NOP1pr-GFP in SD
cell periphery,punctate91.7732 -
N' TEF2pr-mCherry in SD
cell periphery,punctate,bud neck43.5405 -
N' NATIVEpr-GFP in SD
cell periphery,punctate,bud neck47.5578 -
N' TEF2pr-VC and Cyto-VN in SD
punctate34.9845 -
C’ GFP library in SD+DTT

punctate45.790.88No -
C’ GFP library in SD+H2O2

punctate46.910.9No -
C’ GFP library in Starvation Media

punctate86.531.67Yes -
C’ GFP library on the background of Pup2-DaMP

punctate -
C’ GFP library on the background of CCT mutant

punctate53.37721.03257No
